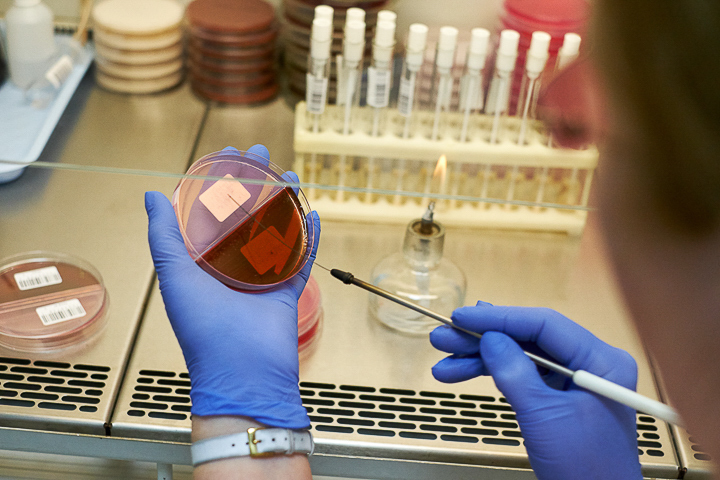

Сдать тест на коронавирус в спб бесплатно курортный район
В связи с большим количеством вопросов разъясняем порядок прохождения тестирования на коронавирус (COVID-19) в нашей больнице.
Тестирование на бесплатной основе
Тестирование на бесплатной основе проводится для пациентов:
- по направлению на госпитализацию в Городскую больницу №40;
- по направлению терапевта поликлиник Курортного района (№68,69,70). Результат забирается у своего участкового врача-терапевта (Срок ожидания результата 1-5 дней).
- Для сдачи теста необходимо оформить направление в кабинете №113 ПО №68 (с 9:00 - 17:00).
- Тестирование не анонимно! Для сбора анамнеза необходимо ответить на вопросы специалиста и сообщить свои персональные данные.
Просим Вас обратить особенное внимание:
- При симптомах ОРВИ просим вас оставаться дома и вызывать врача на дом!
Тестирование проводится:
с 9:00 до 10:00 - пациенты, поступающие на госпитализацию;
с 11:30 до 12:00 - пациенты, имеющие направление от терапевта
ВНИМАНИЕ!
МЕСТО ПРОВЕДЕНИЯ ТЕСТИРОВАНИЯ:
ПТД №10, ул. Борисова, дом 7-А .
Тестирование на платной основе
Стоимость 1500 рублей, срок ожидания результата – 1 день
Сдача теста возможна для всех желающих ежедневно с 9:00 до 16:00 по предварительной записи .
Мазок берётся из носоглотки. Для сдачи теста необходимо подойти в корпус реабилитации (корп. №6, 1 эт., каб. 57) и оформить договор.
Результаты, заверенные печатью больницы, можно получить на следующий день:
- Viber (отправка результата платная - стоимость 150 руб.);
- WhatsApp (отправка результата платная - стоимость 150 руб.);
- на электронную почту (отправка результата платная - стоимость 150 руб.).
Приоритеты
В соответствии с методическими рекомендациями Главного государственного санитарного врача Российской Федерации от 30.04.2020 г. № МР 3.1.0175-20 лабораторное обследование подлежащих (обязательных) контингентов в условиях распространения COVID-19 целесообразно проводить, исходя из приоритетов (первоочередности) групп риска, в том числе в целях недопущения задержки проведения исследований и оперативной организации проведения противоэпидемических мер.
Приоритеты 1-го уровня:
- лица, прибывшие из-за рубежа с наличием симптомов инфекционного заболевания (или при появлении симптомов в течение периода медицинского наблюдения);
- контактные лица с больными COVID-19 при выявлении и при наличии симптомов, не исключающих COVID-19;
- лица с «внебольничной пневмонией»;
- медицинские работники, имеющие риск инфицирования (скорая (неотложная) медицинская помощь, инфекционные отделения, отделения для больных внебольничной пневмонией) при появлении симптомов, не исключающих COVID-19;
- лица при появлении респираторных симптомов, находящихся в закрытых коллективах по длительному уходу (интернаты, пансионаты для пожилых и другие учреждения).
Приоритеты 2-го уровня:
- лица старше 65-лет при появлении респираторных симптомов;
- медицинские работники, имеющие риск инфицирования (скорая (неотложная) медицинская помощь, инфекционные отделения, отделения для больных внебольничной пневмонией) 1 раз в неделю (до появления Ig G).
Приоритеты 3-го уровня:
- организованные коллективы детей (открытого типа) при возникновении 3-х и более случаев заболеваний, не исключающих COVID-19 обследуются, как при вспышечной заболеваемости.
Иные контингенты относятся к приоритетам более низкого уровня.
Лабораторное обследование лиц на COVID-19, относящихся к приоритетам более низкого уровня (в том числе лиц, желающих обследоваться самостоятельно) проводится в ПТД № 10 СПб ГБУЗ «Городская больница № 40» (г. Сестрорецк, ул. Борисова, д. 7 А) по графику, представленному выше.
Где быстрее и дешевле сдать тест на коронавирус в Петербурге?
В Петербурге коронавирусом заболевают более 900 человек ежедневно. Узнать, попали ли вы в их число, можно с помощью теста ПЦР. «Фонтанка» напоминает, где и как его можно сдать.

Фото: Михаил Огнев/«Фонтанка.ру»/Архив
Что такое тест на коронавирус?
Основной способ выявления коронавирусных больных — тест на основе полимеразной цепной реакции (ПЦР). Это молекулярно-генетический анализ, который помогает определить возбудителя инфекции — РНК SARS-CoV-2 в организме человека. Если коронавирусные частицы есть, ПЦР даст положительный результат, даже если человек чувствует себя здоровым.
Чем отличается ПЦР от антигенного теста?
Как и ПЦР, тесты на антигены предназначены для обнаружения вируса, вызывающего COVID-19. Результаты такого теста обычно становятся известны быстрее и стоят они дешевле, чем при тестировании методом ПЦР, но большинство из них показывают более низкую чувствительность, то есть способность тестов на антиген выявлять COVID-19 хуже. Поэтому, как правило, для допуска на мероприятия или для поездки и при возвращении из-за границы требуют именно ПЦР-тест.
Если я чувствую симптомы коронавируса, положен ли мне бесплатный тест?
ПЦР-тестирование граждан «по желанию» в Петербурге не проводится, так как не является страховым случаем, следует из разъяснений петербургского комздрава. Бесплатно диагностика на COVID-2019 положена только тем, кто имеет направление от лечащего врача.
Врач принимает решение, исходя из клинической картины и эпидемиологического анамнеза. Если у пациента, по его мнению, классическая ангина или гайморит, нет повышенной температуры, других симптомов, характерных для COVID-19, и не было контакта с больными коронавирусной инфекцией, то тест, скорее всего, не назначат.
Как убедить врача дать направление на бесплатный ПЦР-тест?
Выдавая направления на ПЦР-анализ, врачи отдают приоритет нескольким группам. Больше всего шансов получить направление, если вы:
— прилетели из-за границы и имеете симптомы ОРВИ;
— контактировали с больными COVID-19 и имеете симптомы ОРВИ;
— заболели внебольничной пневмонией;
— являетесь медицинским работником, имеющим риск инфицирования;
— проживаете в интернате или ином учреждении социального обслуживания и имеете симптомы ОРВИ;
— вам больше 65 лет и у вас есть симптомы ОРВИ;
— вы ребенок, находящийся в организованных коллективах, в которых выявлено три и более случаев COVID-19;
— обратились за медицинской помощью и имеете симптомы, характерные для коронавирусной инфекции.
Кто обязан сдавать тест на коронавирус?
Все граждане РФ, прибывающие из-за рубежа любым видом транспорта, со 2 мая обязаны проходить двойное ПЦР-тестирование на коронавирус. Первый тест на коронавирус необходимо сдать в течение трех дней с момента прибытия. Второй тест на COVID-19 должен быть сдан в течение 5 дней. Интервал между двумя тестами — 1 сутки.
Первый тест надо загрузить на Госуслуги не позднее трех суток после прибытия, второй — не позднее 5 суток. Двойное ПЦР-тестирование обязательно и для тех россиян, кто привит от ковида. Единственная страна, при возвращении из которой можно не сдавать тесты, это Абхазия.
Согласно разъяснениям на сайте «Стопкоронавирус», также анализ необходимо делать:
— всем, кто контактировал с зараженными;
— людям с внебольничной пневмонией;
— людям старше 65 с симптомами респираторного заболевания;
— врачам с риском инфицирования COVID-2019 на рабочих местах;
— всем, кто находится в учреждениях постоянного пребывания (например, кадетские корпуса, дома-интернаты, учреждения ФСИН) с симптомами респираторного заболевания.
Может ли работодатель обязать сотрудника сдать тест на коронавирус?
У работодателя нет правовых оснований требовать от сотрудника справки на отрицательный результат теста на коронавирус, как и самого прохождения теста, следует из разъяснений Минтруда.
Кто делает тесты на коронавирус?
Сейчас ПЦР-тестирование на COVID-19 в Петербурге осуществляется в 55 лабораториях. Две из них это лаборатории Роспотребнадзора — Центр гигиены и эпидемиологии и лабораториях НИИ Пастера. Анализы амбулаторных пациентов, пациентов с подозрением на коронавирус, контактных, а также медработников обрабатываются в лаборатории 36 медицинских организаций. Также делать исследования могут 17 частных лабораторий. Условие одно: передавать сведения о положительных результатах тестирования в медицинское ведомство.
Где можно сдать тест на коронавирус?
При наличии направления врача пациенты с подозрением на COVID-19 сдают ПЦР-тест в поликлинике. Но они должны заходить с отдельного входа и осматриваться специально выделенным персоналом. Пациенты с подтвержденным COVID-19 обязаны соблюдать самоизоляцию, так что врач или медсестра придут к ним на дом для взятия мазка.
Мест, где в Петербурге можно сдать анализ на платной основе, несколько десятков. Мазки берут практически все частные клиники. Они также предлагают услуги тестирования с выездом на дом и предприятия, устанавливают мобильные пункты возле станций метро или предлагают сдать мазок, не выходя из своей машины, — варианты есть на любой вкус и кошелек. А вот обрабатывать анализы отправляют в названные выше аккредитованные лаборатории, причем не только в частные, но и государственные. Например, аэропорт Пулково отправляет их в Центр гигиены и эпидемиологии Роспотребнадзора.
Сколько стоит тест на коронавирус в Петербурге?
Цена зависит от срочности, но не всегда. Из нескольких десятков предложений, которые проанализировала «Фонтанка», самый доступный вариант оказался в аккредитованной лаборатории «Эксплана»: 1400 рублей, выезд курьера в пределах КАД — плюс 400 рублей. Результаты обещают через 1– 3 дня.
Еще одна аккредитованная лаборатория «Лабтест» предлагает провести анализ за 1500 рублей с результатами через 1–3 дня. Но анализ примут только при отсутствии признаков ОРВИ и с условием, что вы не контактировали с больными.
Где быстрее всего сделать платный тест на коронавирус?
Самый быстрый вариант, который удалось найти «Фонтанке», предлагает Helix. Результат будет готов всего за один час, правда за такую услугу попросят 8290 рублей и сдать анализ можно только в одном месте — центре на Карповке. Анализ в течение суток (без учета дня забора) будет стоить 2490 рублей. В качестве бонуса — справка на 16 языках.
«Лабтест» предлагает обработать результат на следующий день за 3300 рублей, «Эксплана» за 2400 рублей в течение суток.
Где сдать платный тест на коронавирус, если у меня симптомы ОРВИ?
Большинство частных клиник готово принимать анализы лишь у потенциально здоровых людей. Немецкая семейная клиника берет мазки в фильтр-боксе или из машины за 1490 рублей. Результат придется ждать 48 часов (не считая дня забора). Другие предлагают бесконтактный тест на дому. Например, у Helix услуга стоит 1900 рублей с результатом через двое суток или 2600 рублей за сутки. У «Экспланы» набор для бесконтактного анализа с доставкой в пределах КАД стоит 1500 рублей (результат через 1–3 дня) или 2500 рублей (результат в течение суток).
Насколько точен результат ПЦР-теста на коронавирус?
Результат может оказаться как ложноположительным, так и ложноотрицательным. В самом тесте заложена погрешность на несколько процентов. Но смазать картину могут также некачественный забор мазка и нарушения условий транспортировки образца. Комитет по здравоохранению предлагает больше верить положительным результатам и сразу отправляться на самоизоляцию. Чтобы считаться выздоровевшим, достаточно получить один отрицательный тест.
На середину июня 2021 года петербуржцы сдают по 20–40 тысяч ПЦР-тестов на коронавирус в день, более 900 оказываются положительными.
Как пройти тест на коронавирус бесплатно?
Если вы уже чувствуете симптомы ОРВИ (кашель, насморк, боль в горле, температура, слабость, затрудненное дыхание и т. д.), позвоните в регистратуру вашей больницы или по телефону горячей линии. Нужно рассказать о симптомах и вызвать участкового врача на дом. Врач придет для осмотра и скажет, нужно ли сдавать тест. Возможно, он сразу возьмет мазок для ПЦР-теста (о видах тестов на COVID расскажем ниже).
При тяжелом течении заболевания нельзя медлить, выбирая вариант тестирования. Сразу же вызывайте скорую помощь.
Бесплатный тест могут получить следующие лица:
- Все, кто контактировал с больным коронавирусом;
- Все пациенты с симптомами простуды по назначению врача: кашель, насморк, боль в горле, температура, слабость, затрудненное дыхание и т. д.;
- Все люди с диагнозом «внебольничная пневмония»;
- Все пожилые люди старше 65 лет с симптомами простуды;
- Все медицинские работники с симптомами ОРВИ, а также те специалисты, которые работают в условиях высокого риска инфицирования (каждую неделю);
- Все лица с симптомами простуды, которые проживают в учреждениях с постоянным пребыванием: учебно-воспитательные, кадетские корпусы, интернаты, учреждения ФСИН России. Персонал учреждений также сдает анализы.
Тест на коронавирус в Санкт-Петербурге: где можно сдать, как проходит и сколько стоит

Каждый день в Санкт-Петербурге от 3 до 14 тысяч человек сдают тест на коронавирус, чтобы выяснить, есть ли у них эта новая болезнь. Зачастую заболевание проходит совсем без симптомов, либо же с минимальным ухудшением здоровья. Тем не менее, знать о том, заражен ты или нет важно, чтобы не передать инфекцию дальше. «Комсомолка» собрала последние сведения о том, где можно сдать тест на коронавирус в Санкт-Петербурге, как проходит и сколько стоит.
КАК ПРОХОДИТ
Забор анализов на коронавирус проходит всего за пару минут. У тестируемого берут мазки из носа и горла специальными стерильными палочками. После этот материал плотно запечатывается и отправляется в лабораторию. Результаты тестирования, в зависимости от места сдачи, приходят через 3-4 дня, порой 2 недели.

Сдать тест на коронавирус платно можно во многих частных клиниках. Результаты анализа пациент получит быстро, в течение 3-5 дней. Стоимость такого тестирования в Петербурге варьируется от 1200 до 4000 тысяч рублей.ГДЕ СДАТЬ
Также в Санкт-Петербурге можно бесплатно сдать тест на коронавирус. Анализы принимают в городских поликлиниках у всех желающих.
Список пунктов сдачи анализов на коронавирус в Санкт-Петербурге:
Адмиралтейский район
Городская поликлиника №24 (взрослое отделение - набережная Обводного канала 140, детское отделение - набережная Обводного канала 123);
Городская поликлиника №27 (взрослое отделение – Вознесенский проспект, 29А, детское отделение – улица Глинки 8);
Городская поликлиника №28, Подъездной переулок 2;
Василеостровский район
Городская поликлиника №4, Большой проспект ВО 59А;
Городская поликлиника №4, Наличная улица 37А;
Детское поликлиническое отделение № 1, Городская поликлиника № 4, улица Кораблестроителей 21/2, литера А, Б;
Детское поликлиническое отделение №5, Городская поликлиника № 3, 7-я линия ВО 64;
Городская поликлиника №3, Железноводская улица 64;
Городская поликлиника №3, 3-я линия ВО 50;
Детское поликлиническое отделение № 24, Городская поликлиника № 3, улица Кораблестроителей 31/2;
Калининский район
Городская поликлиника №86, Кришская улица 5/3;
Городская поликлиника №76, проспект Непокоренных 8/2;
Городская поликлиника №54, улица Комсомола 14;
Городская поликлиника №96, проспект Просвещения 53/2;
Городская поликлиника №112, улица Академика Байкова 25/1;
Городская поликлиника №118, улица Академика Байкова 27;
Детская городская поликлиника №29, Тимуровская улица 17/2;
Кировский район
Городская поликлиника №23, улица Косинова 17А;
Городская поликлиника №43 отделение врачей общей практики №2, улица Лени Голикова 35;
Городская поликлиника №88 детское отделение «25, улица Танкиста Хрустицкого 3;
Колпинский район
Городская поликлиника №71, Колпино, Павловская улица 10А;
Красносельский район
Городская поликлиника №91 и детское отделение №65, улица Отважных 12А;
Городская поликлиника №93, улица Освобождения 15;
Детское поликлиническое отделение №28, улица Освобождения 13, бокс;
Городская поликлиника №106, улица Маршала Захарова 16/1;
Курортный район
Городская больница №40, Сестрорецк, улица Борисова 7-А;
Московский район
Городская поликлиника №51, проспект Космонавтов 33-35;
Детское поликлиническое отделение №31, улица Орджоникидзе 38;
Детское поликлиническое отделение №39, проспект Космонавтов 54;
Городская поликлиника №75, улица Кузнецовская 9;
Городская поликлиника №21, улица Костюшко 6;
Городская поликлиника №48, улица Бассейная 19, ( отделение №47 Благодатная улица 18);
Детская городская поликлиника №35, улица Костюшко 4, (отделение №47, Ленинский проспект 186/2);
Петродворцовый район
Городская поликлиника №122, Ломоносов, улица Красного Флота 13;
Николаевская больница, Петергоф, улица Царицынская 1;
Приморский район
Городская поликлиника №49, Ланская улица 12, отделение №33, улица Оскаленко 18, отделение №63, Лисий Нос, Морской проспект 3;
Детское поликлиническое отделение №20 Городская поликлиника №49, Школьная улица 16;
Городская поликлиника №98, Серебристый бульвар 14/1;
Городская поликлиника №102, проспект Королева 5;
Детская поликлиника №30, проспект Королева 3/2 (отделение №2, Вербная улица 16, отделение №2, Серебристый бульвар 14/2);
Городская поликлиника №111, Ольховая улица 6, детское поликлиническое отделение №77, Ольховая улица «;
Городская поликлиника №114, Школьная улица 116/1 (отделение №115, Шаврова 19/1, отделение №121, Камышовая 50/1, детское отделение «16, Школьная улица 114/1, детское отделение №50, Лыжный переулок 5, детское отделение №70, Камышовая 48/2, детское отделение №75, улица Шаврова 21/2);
Пушкинский район
Детская городская поликлиника №60, Павловск, улица Мичурина 3;
Городская поликлиника №60, Пушкин, улица Московская 15;
Городская поликлиника №60, Шушары, улица Первомайская 20;
Фрунзенский район
Городская поликлиника №44, Будапештская улица 20;
Городская поликлиника №78, Будапештская улица 63/2;
Городская поликлиника №109, улица Олеко Дундича 8/2;
Центральный район
Городская поликлиника №37, улица Правды 18 (детское отделение №37, Загородный проспект 29);
Городская поликлиника №39, Малая Конюшенная улица 2;
Детская поликлиника №44, Мытнинская улица 25;
Детская поликлиника №8, улица Чайковского 73.
СЛУШАЙТЕ ТАКЖЕ:
Аудио: ТЕМА ДНЯ в Петербурге. Коронавирус убивает даже тех, кто им не болен
СЛУШАЙТЕ ТАКЖЕ:
Аудио: ТЕМА ДНЯ в Петербурге. Коронавирус убивает даже тех, кто им не болен
Возрастная категория сайта 18 +
Ответы на частые вопросы
Здесь вы найдете ответы на часто задаваемые вопросы по поводу тестирования.
Как мне подготовиться к тесту?
Процесс подготовки зависит от вида теста.
К тесту на сам вирус
Какие рекомендации в этом случае:
- Не есть, не пить, не чистить зубы и не курить минимум за 2 часа до теста;
- За полчаса не жевать жвачку и не рассасывать конфеты, не полоскать горло. Не пользоваться спреем для горла, каплями для носа и другими лекарственными средствами;
- Если нос заложен, высморкаться перед процедурой.
К тесту на антитела
Не есть до сдачи крови за 4 часа. Воду пить можно. Так медсестре будет проще взять биоматериал.
Какие документы необходимы для тестирования?
Когда врач или скорая приедут на дом, необходимо предоставить специалисту паспорт и полис ОМС. Те же документы возьмите с собой в клинику, если симптомов болезни нет.
Что делать в случае положительного результата?
Если коронавирус подтвердится, о диагнозе сообщат в Роспотребнадзор. Тест повторят еще один раз, если симптомов нет. Если есть, еще два раза. Если повторный анализ будет положительным, человека поместят в карантин в зависимости от течения болезни. В легких случаях лечение будет на дому. В тяжелых – организуют госпитализацию.
При домашнем лечении нужно следить за самочувствием. При ухудшении состояния вызвать врача либо скорую (если ухудшение резкое).
Через 14 дней тест нужно сделать повторно два раза. Если два раза будет отрицательный результат, вам закроют больничный и вы сможете выйти из карантина.
Может ли быть тест ложноположительным или ложноотрицательным?
Да, может. Если тест выдал положительный результат в первый раз, это лишь подтверждает вероятность наличия вируса. Отрицательный тест тоже не говорит о стопроцентном отсутствии COVID-19. Если симптомы есть, а тест отрицательный, его повторяют через сутки-двое. Чем больше времени прошло с момента заражения, тем легче диагностировать коронавирус.
В связи с большим количеством вопросов разъясняем порядок прохождения тестирования на коронавирус (COVID-19) в нашей больнице.
Тестирование на бесплатной основе
Тестирование на бесплатной основе проводится для пациентов:
- по направлению на госпитализацию в Городскую больницу №40;
- по направлению терапевта поликлиник Курортного района (№68,69,70). Результат забирается у своего участкового врача-терапевта (Срок ожидания результата 1-5 дней).
- Для сдачи теста необходимо оформить направление в кабинете №113 ПО №68 (с 9:00 - 17:00).
- Тестирование не анонимно! Для сбора анамнеза необходимо ответить на вопросы специалиста и сообщить свои персональные данные.
Просим Вас обратить особенное внимание:
- При симптомах ОРВИ просим вас оставаться дома и вызывать врача на дом!
Тестирование проводится:
с 9:00 до 10:00 - пациенты, поступающие на госпитализацию;
с 11:30 до 12:00 - пациенты, имеющие направление от терапевта
ВНИМАНИЕ!
МЕСТО ПРОВЕДЕНИЯ ТЕСТИРОВАНИЯ:
ПТД №10, ул. Борисова, дом 7-А .
Тестирование на платной основе
Стоимость 1500 рублей, срок ожидания результата – 1 день
Сдача теста возможна для всех желающих ежедневно с 9:00 до 16:00 по предварительной записи .
Мазок берётся из носоглотки. Для сдачи теста необходимо подойти в корпус реабилитации (корп. №6, 1 эт., каб. 57) и оформить договор.
Результаты, заверенные печатью больницы, можно получить на следующий день:
- Viber (отправка результата платная - стоимость 150 руб.);
- WhatsApp (отправка результата платная - стоимость 150 руб.);
- на электронную почту (отправка результата платная - стоимость 150 руб.).
Приоритеты
В соответствии с методическими рекомендациями Главного государственного санитарного врача Российской Федерации от 30.04.2020 г. № МР 3.1.0175-20 лабораторное обследование подлежащих (обязательных) контингентов в условиях распространения COVID-19 целесообразно проводить, исходя из приоритетов (первоочередности) групп риска, в том числе в целях недопущения задержки проведения исследований и оперативной организации проведения противоэпидемических мер.
Приоритеты 1-го уровня:
- лица, прибывшие из-за рубежа с наличием симптомов инфекционного заболевания (или при появлении симптомов в течение периода медицинского наблюдения);
- контактные лица с больными COVID-19 при выявлении и при наличии симптомов, не исключающих COVID-19;
- лица с «внебольничной пневмонией»;
- медицинские работники, имеющие риск инфицирования (скорая (неотложная) медицинская помощь, инфекционные отделения, отделения для больных внебольничной пневмонией) при появлении симптомов, не исключающих COVID-19;
- лица при появлении респираторных симптомов, находящихся в закрытых коллективах по длительному уходу (интернаты, пансионаты для пожилых и другие учреждения).
Приоритеты 2-го уровня:
- лица старше 65-лет при появлении респираторных симптомов;
- медицинские работники, имеющие риск инфицирования (скорая (неотложная) медицинская помощь, инфекционные отделения, отделения для больных внебольничной пневмонией) 1 раз в неделю (до появления Ig G).
Приоритеты 3-го уровня:
- организованные коллективы детей (открытого типа) при возникновении 3-х и более случаев заболеваний, не исключающих COVID-19 обследуются, как при вспышечной заболеваемости.
Иные контингенты относятся к приоритетам более низкого уровня.
Лабораторное обследование лиц на COVID-19, относящихся к приоритетам более низкого уровня (в том числе лиц, желающих обследоваться самостоятельно) проводится в ПТД № 10 СПб ГБУЗ «Городская больница № 40» (г. Сестрорецк, ул. Борисова, д. 7 А) по графику, представленному выше.
Резюме: зачем и когда сдавать тест
Тестироваться на коронавирус можно бесплатно, но только если у вас есть симптомы простуды. И то по назначению врача. С симптомами нельзя идти в частную клинику, чтобы избежать распространения. В этих случаях тестируют на дому либо при госпитализации.
За деньги проходить тест можно в таких случаях:
- Нужна справка об отсутствии COVID при выезде из страны или региона, при рабочих контактах с большим количеством людей. Человек может быть бессимптомным носителем вируса;
- Хочется узнать, болели ли вы COVID ранее или заразились им сейчас. В том случае если признаков болезни нет;
- Вы приехали из-за границы. В течение 3 дней вы должны предоставить результаты отрицательного теста на сайте Госуслуг.
Важно! Если платный анализ выявит COVID, попасть в стационар по результатам коммерческого теста вам не удастся. Придется все равно обращаться в государственную поликлинику. Если симптомов нет, врач не назначит вам тестирование. Таким образом, если вы подозреваете, что у вас COVID, но симптомов при этом нет, самоизолируйтесь и следите за симптомами. Либо позвоните на горячую линию для получения дальнейших инструкций.
Где можно сдать тест на коронавирус платно в Сестрорецке?
Платно пройти тест можно в частной клинике, без направления врача. Ниже список учреждений в Сестрорецке, где сдавать анализы:
Сдать тест на коронавирус в спб бесплатно курортный район
Желающие провериться на коронавирус петербуржцы должны платить. В комздраве объяснили, почему это не входит в ОМС
15.10.2020 09:59Обследование на вирус COVID-19 не является страховым случаем в рамках программы ОМС. Об этом «Фонтанке» 14 октября сообщили в комитете по здравоохранению Санкт-Петербурга.
Мартовское постановление главного государственного санитарного врача РФ Анны Поповой предписывает организовать в регионах диагностику на коронавирус с привлечением всех лабораторий вне зависимости от их организационно-правовой формы. При этом анализы обязаны сдавать все контактировавшие с заболевшими COVID-2019, пациенты с диагнозом «внебольничная пневмония», все вернувшиеся из-за границы с признаками респираторных заболеваний, имеющие такие симптомы граждане старше 65 лет, а также сотрудники СИЗО, колоний, домов-интернатов.
Вместе с тем в комитете по здравоохранению констатируют, что бесплатно лабораторная диагностика на COVID-2019 положена только для тех, кто имеет направление от лечащего врача.
«Обследование граждан «по желанию» не является страховым случаем, подлежащим оплате за счет средств обязательного медицинского страхования (ОМС), так как не осуществляется в целях лечения или диагностики имеющегося заболевания», — поясняет глава отдела по организации амбулаторной медицинской помощи комитета Лариса Соловьева.
Также в медицинском ведомстве Смольного отмечают, что само исследование должно проводиться в течение не более 48 часов с момента получения пробы. Еще сутки отводят на передачу результатов в заказавшие анализ клиники.
В настоящее время все возвращающиеся из-за границы россияне должны в течение трех суток сдать анализ на COVID-2019 и загрузить результаты на Единый портал государственных и муниципальных услуг. Как объяснили в Роспотребнадзоре, такие граждане обязаны пройти обследование в аэропорту или по дороге к месту жительства, а потом до получения результата оставаться дома.
Виды тестов и их особенности
Тесты делят на две большие группы:
- На обнаружение самого вируса. Берут мазок из горла. Используют метод ПЦР;
- На обнаружение антител. Их вырабатывает иммунитет, когда вирус попадает в организм. Сдается кровь.
Эти тесты обычно проходят люди с симптомами простуды, ОРВИ, гриппа и пневмонии. По показанию врача бесплатно или платно в частных клиниках.
Ехать с симптомами в платную лабораторию нельзя, так как есть риск заразить других людей. Сотрудники не имеют права брать материал у заболевшего человека.
Если вы заболели, оставайтесь дома и вызовите врача. Он уже скажет, что делать. Либо если течение болезни легкое, закажите в частной клинике самостоятельное взятие материала с доставкой на дом. Курьер подождет за дверью, заберет материал. Результат теста отправят на электронную почту.
2 -Тесты на антитела (сдача крови на иммуноглобулины IgM, IgG, IgA)
Важно! Антитела не вырабатываются сразу, как только вирус попал в организм. В зависимости от состояния иммунитета защитные клетки появляются в период от нескольких дней до нескольких недель. В среднем это 7-14 суток. Поэтому для диагностики такие тесты не используют.
Для чего делают тест на антитела:
- Понять (врачам), насколько эффективно организм борется с заболеванием. Когда COVID уже диагностирован;
- Определить статистику (эпидемиологам и работодателям): сколько человек уже переболело в регионе или коллективе;
- Узнать, переболели вы коронавирусом или нет.
Важно! Наличие антител IgG не говорит о том, что человек больше не заболеет коронавирусом. Специалисты все еще изучают вопрос о стойком иммунитете к COVID.
Тесты на антитела к коронавирусу делят на две группы:
- Сложные. Проводятся в лаборатории. С полноценным забором крови. Можно приехать в саму клинику или лабораторию. Либо вызвать медсестру на дом, чтобы сдать кровь. После этого материал отправят на диагностику. Результат вышлют по электронной почте;
- Экспресс-тесты. В специальный картридж помещается капля крови с каплей буферного раствора. Через 10-15 минут появляется результат. Его можно проводить и в клинике, и самостоятельно (заказать бесконтактную доставку на дом). Последний вариант удобен, если не хочется выходить на улицу и контактировать с другими людьми.
Как расшифровать результаты теста на антитела
Какие могут быть варианты:
- Если антитела IgG и IgM отсутствуют, значит, вы не сталкивались с коронавирусом. Либо столкнулись, но совсем недавно (иммунитет еще не успел среагировать);
- Если есть антитела IgM, вы перенесли коронавирус недавно или находитесь как раз в периоде выздоровления;
- Если есть антитела IgG, вы перенесли вирус более двух недель назад.
Все петербуржцы с 16 марта могут бесплатно сдать анализ на коронавирус
С 16 марта все жители Санкт-Петербурга смогут совершенно бесплатно сдать анализы на коронавирус. Об этом заявили в городском Комитете по здравоохранению. А заодно обнародовали список поликлиник и больниц, куда могут пойти желающие провериться.
- Анализ в виде мазка из носоглотки проводится бесплатно. Пройти проверку могут все желающие уже с сегодняшнего дня, - сообщает пресс-служба ведомства.
Бежать сломя голову никого не призывают, но адреса себе лучше записать. «Комсомольская правда» публикует весь список учреждений по районам, где берут анализы.
Адмиралтейский: Во всех амбулаторно-поликлинических учреждениях района для взрослых
Василеостровский: Во всех амбулаторно-поликлинических учреждениях района для взрослых
Выборгский: Городская поликлиника № 52, по адресу: ул. Ломоносова, д. 76
Калининский: СПб ГБУЗ «Городская поликлиника № 112» по адресу: ул. Акад. Байкова, д. 25, к. 1; СПб ГБУЗ «Городская поликлиника № 96», по адресу: пр. Просвещения, д. 53, к. 2; СПб ГБУЗ «Городская поликлиника № 86», по адресу: Киришская ул., д. 5, к. 3; СПб ГБУЗ «Городская поликлиника № 54», ул. Васенко, д. 9; СПб ГБУЗ «Городская поликлиника № 118» по адресу: ул. Акад. Байкова, д. 27; СПб ГБУЗ «Детская городская поликлиника № 29», по адресу: ул. Демьяна Бедного, д. 18., к. 3
Кировский: СПб ГБУЗ «Городская поликлиника № 43», по адресу: ул. Лени Голикова, д. 35
Колпинский: Во всех амбулаторно-поликлинических учреждениях района для взрослых и детей
Красногвардейский: Поликлиническое отделение № 103 СПб ГБУЗ «Городская поликлиника № 107», по адресу: Малоохтинский пр., д. 96а; Поликлиническое отделение № 34 СПб ГБУЗ «Детская городская поликлиника № 68», по адресу: пр. Шаумяна, д. 29, к. 2
Красносельский: СПб ГБУЗ «Городская поликлиника № 106», по адресу: ул. Маршала Захарова, д. 16; 2. СПб ГБУЗ «Городская поликлиника№ 93», по адресу: ул. Освобождения,д. 15
Кронштадтский: СПб ГБУЗ «Городская поликлиника № 74», по адресу: ул. Комсомола, д. 2
Курортный: Поликлиническое отделение № 68 СПб ГБУЗ «Городская больница № 40 Курортного района», по адресу: г. Сестрорецк, ул. Борисова, д. 9,каб. 139
Московский: Во всех амбулаторно-поликлинических учреждениях для взрослых и детей
Невский: Во всех амбулаторно-поликлинических учреждениях для взрослых и детей
Петроградский: СПб ГБУЗ «Городская поликлиника № 32», по адресу: пер. Вяземский, д. 3; СПб ГБУЗ «Городская поликлиника № 34», по адресу: Зверинская ул., д. 15; СПб ГБУЗ «Городская поликлиника № 30», по адресу: ул. Малая Зеленина, д. 6; Детское поликлиническое отделение СПб ГБУЗ«Городская поликлиника № 30», по адресу: Малый пр., ПС, д. 15; СПб ГБУЗ «Детская городская поликлиника № 19», по адресу: ул. Куйбышева, д. 25; Поликлиника с КДЦ Первого СПб ГМУ им. И.П. Павлова», по адресу: ул. Л. Толстого, д. 6-8
Петродворцовый: СПб ГБУЗ «Городская поликлиника № 122», по адресу: г. Ломоносов, ул. Красного Флота, д. 13, каб. 137; СПб ГБУЗ «Николаевская больница», по адресу: г. Петергоф, ул. Царицынская, д. 1, каб. 111
Приморский: Во всех амбулаторно-поликлинических учреждениях района для взрослых и детей
Пушкинский: Во всех амбулаторно-поликлинических учреждениях района для взрослых и детей
Фрунзенский: Во всех амбулаторно-поликлинических учреждениях района для взрослых и детей
Центральный: Во всех амбулаторно-поликлинических учреждениях района для взрослых и детей.
Возрастная категория сайта 18 +
Наберитесь терпения и ждите звонка: Как мы сдавали анализы на коронавирус в поликлинике Санкт-Петербурга

Для борьбы с распространением китайского коронавируса власти Санкт-Петербурга пошли на очень важный и полезный шаг: если раньше, чтобы сдать анализы на заморскую заразу, нужно было обязательно ложиться на две недели в инфекционку, то теперь это можно сделать в любой больнице или поликлинике. Так, по крайней мере, задумывалось. «Комсомолка» проверила новую систему на практике и убедились — в ней пока что достаточно сбоев.
УСПЕЛИ НЕ ВСЕ
В первой же поликлинике, куда мы обратились, чтобы сдать анализы, нас встретили отказом.
- Вы уже не первые, кто нас с утра об этом спрашивает, - почему-то очень волнуясь, объяснила женщина-врач, ведущая прием больных с симптомами ОРВИ. - Вы поймите, у нас ничего еще не готово. Пробирок нет, медсестры не обучены. Мы этот вопрос решаем. Возможно, завтра-послезавтра все заработает как нужно.

Ситуация повторилась еще в нескольких городских поликлиниках. Где-то нам просто отказали по тем же самым причинам, где-то — попросили перезвонить ближе к середине дня, потому что «процесс подготовки идет прямо сейчас». Нет во врачах согласия и насчет того, кто и как может сдать анализы: в одном месте медрегистратор потребовал направление от терапевта, в другом — от инфекциониста, в третьем — прикрепление к конкретному учреждению и так далее.
Впрочем, такой хаос творится все-таки не везде. Отдельные поликлиники сумели напрячься и в максимально сжатые сроки сделать все, что нужно. И мы такую тоже пусть и не сразу, но отыскали. Во Фрунзенском районе, на улице Будапештской — вдруг кому пригодится.

КАК ДЕЛАЕТСЯ АНАЛИЗ НА КОРОНАВИРУС
Анализы на коронавирус берутся в отдельном помещении с собственным входом. Зайти внутрь можно только в медицинской маске, на столике в тамбуре — антибактериальные салфетки, чтобы можно было протереть руки и мобильный телефон. Комната, в которой сидит специалист, постоянно обеззараживается ультрафиолетом, несколько раз в день оставшиеся бациллы добивают кварцеванием. Сама процедура занимает всего несколько секунд: пациенту специальными длинными палочками берут мазки из обеих ноздрей и глотки. То, что осталось на палочке, отправляется в пластиковые пробирки с герметичными крышечками, пробирки маркируются и ставятся в холодильник. Оттуда их раз в сутки забирают и отвозят в Центр гигиены и эпидемиологии. И вот тут-то кроется еще одна неприятная загвоздка: результата, по словам врачей, придется ждать три недели. Раньше никак: поликлиник в городе много, людей, которые хотят провериться на коронавирус, еще больше (там, где мы были, всего за четыре часа с момента открытия успели взять анализы у 22 человек), а Центр всего один.
- Если анализ окажется положительным, с вами тут же свяжутся по телефону, - проинструктировал нас специалист, бравший мазки. - А на дом к вам выдвинется участковый врач.

«НАБЕРИТЕСЬ ТЕРПЕНИЯ»
Между тем в комитете по здравоохранению обо всех сложностях знают и призывают набраться терпения.
- Подготовительные работы велись в очень оперативном режиме, - рассказали «Комсомолке» в пресс-службе ведомства. - Постановление губернатора вышло только в минувшую пятницу, поэтому в районах этим занимались в выходные. Где-то не успели проинформировать сотрудников регистратур. В отдельных районах возникли проблемы с пробирками — их сейчас дополнительно закупают. Надеемся, что к концу этой либо к началу следующей неделе вся работа в городе будет налажена.
В комитете также уточнили: для того, чтобы сдать анализы на коронавирус, нужны только паспорт и ОМС. Так что если в какой-то поликлинике вас будут посылать за направлением к терапевту или требовать прикрепления — смело стойте на своем. Это значит, что они просто до конца не разобрались в том, как работает новая система. Прикрепление к конкретному учреждению тоже не нужно — достаточно прикрепления к району.

- Что касается сроков — этот момент нужно уточнить, - отметили в пресс-службе. - У нас была информация о том, что результаты будут приходить в течение суток. Возможно, график изменился — все будет зависеть от загрузки Центра гигиены и эпидемиологии.
ВАЖНО!
Если человек с симптомами ОРВИ находится в тяжелом состоянии и у него есть какие-то опасные детали в анамнезе (к примеру, он посещал страны, неблагополучные по коронавирусу, или с кем-то контактировал), то его также отправят в Боткинскую больницу, уточняют в комитете по здравоохранению. Там есть все необходимое: в частности, реанимационное отделение, аппараты искусственной вентиляции легких и аппарат ЭКМО, который насыщает кровь кислородом и используется при тяжелой дыхательной недостаточности.
КОНКРЕТНО
Где сдать тест на коронавирус в Санкт-Петербурге
С 16 марта все жители Санкт-Петербурга смогут совершенно бесплатно сдать анализы на коронавирус. Бежать сломя голову никого не призывают, но адреса себе лучше записать (подробности)
ЧИТАЙТЕ ТАКЖЕ
Совещания в режиме «онлайн» и запрет массовых мероприятий: режим повышенной готовности из-за китайского коронавируса официально ввели в Санкт-Петербурге
Кроме того, всем желающим дадут возможность добровольно обследоваться на инфекцию во всех районах Северной столицы (подробности)
Первый случай коронавируса подтвержден в Ленинградской области
Заболела жительница Кудрово, вернувшаяся из турпоездки в Италию (подробности)
Аудио: Как не заразиться коронавирусом: что реально работает
Жители Репина, где собираются открыть карантинный коронавирусный центр: «Соседству не рады»
Впрочем, многие говорят, что ни потенциально заразные люди, ни сам вирус их не пугает (подробности)
Миллиарды рублей убытков и полное закрытие: как отразится отмена ПМЭФ на ценах в гостиницах Санкт-Петербурга
Зловещий китайский коронавирус, еще не успев толком закрепиться в Северной столице, уже натворил дел: закрыл на карантин в общежитии больше 700 студентов, ударил по туристическому потоку и даже стал причиной отмены Петербургского международного экономического форума. Теперь городские отельеры в панике хватаются за голову: такое решение вкупе с нестабильной международной обстановкой сулит им миллиарды рублей убытков. Впрочем, нет худа без добра (подробности)
ЧИТАЙТЕ ТАКЖЕ
«Повезло тем, у кого страховой стаж больше восьми лет»: как начисляют больничные на карантине
Юрист, финансовый советник и блогер Виктория Шергина рассказала Радио «Комсомольская правда» о том, как рассчитываются больничные при карантине по коронавирусу (подробнее)
Инструкция по выживанию: психолог рассказал, как организовать работу из дома
Психолог Владимир Крупин в интервью Радио «Комсомольская правда» рассказал, как привыкнуть к работе на дому, если вы привыкли все время ходить в офис, но работодатель отправил вас на удаленку (подробнее)
«Нет убедительных данных»: инфекционист сомневается в гибели коронавируса летом
Директор ООО «НИЦ по профилактике и лечению вирусных инфекций», инфекционист Георгий Викулов рассказал Радио «Комсомольская Правда», что никакой уверенности, что эпидемия закончится летом, нет. Ученым только предстоит выяснить, как коронавирус будет чувствовать себя в теплое время года (подробнее)
Возрастная категория сайта 18 +
Сколько стоит и когда будет результат?
Срок и стоимость зависят от типа теста. Метод ПЦР делают за несколько часов, но вместе с транспортировкой материала в лабораторию вся процедура может занять 1-3 дня и более. Экспресс-тест показывает результат в течение нескольких минут.
Цена варьируется в пределах 1000 – 3500 рублей. Отдельно могут взять за забор крови и выезд специалиста на дом. Записаться на тест можно на сайтах клиник или по телефону.
Где можно сдать антитела и ПЦР тест на коронавирус в Сестрорецке
Если вам нужно узнать, где пройти тест на коронавирус в Сестрорецке, звоните:
Читайте также:


